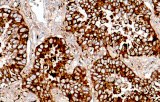
Napsin A

Anticorpos primários para imuno-histoquímica CE/IVD - Cytopatologia
A citopatologia é um ramo da patologia que estuda e diagnostica doenças a nível celular. A citopatologia é a utilização de técnicas de diagnóstico especializadas para examinar células individuais extraídas de tecidos para determinar a causa e a natureza de uma doença.
A citopatologia é normalmente utilizada para investigar doenças que envolvem uma vasta gama de locais do corpo, frequentemente para ajudar no diagnóstico do cancro, mas também no diagnóstico de algumas doenças infecciosas e outras condições inflamatórias. Por exemplo, uma aplicação comum da citopatologia é o Papanicolau, um instrumento de rastreio utilizado para detectar lesões cervicais pré-cancerosas que podem levar ao cancro do colo do útero.
Os testes citopatológicos são por vezes chamados testes de esfregaço porque as amostras podem ser esfregadas através de uma lâmina de microscópio de vidro para posterior coloração e exame microscópico. No entanto, as amostras citológicas podem ser preparadas de outras formas, incluindo a citocentrifugação. Diferentes tipos de testes de esfregaço também podem ser utilizados para o diagnóstico do cancro. Neste sentido, é denominado esfregaço citológico.